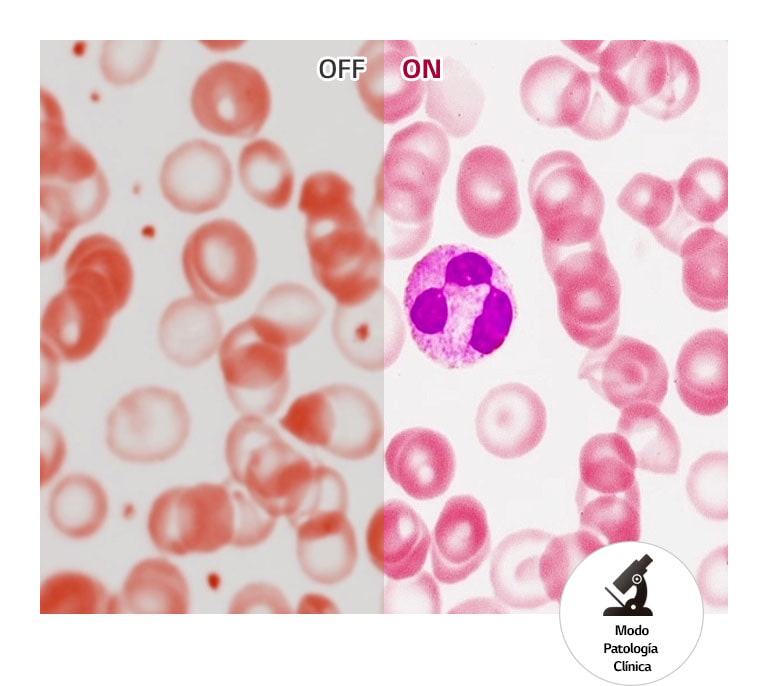

We use cookies, including cookies from third parties, to enhance your user experience and the effectiveness of our marketing activities. These cookies are performance, analytics and advertising cookies, please see our Privacy and Cookie policy for further information. If you agree to all of our cookies select “Accept all” or select “Cookie Settings” to see which cookies we use and choose which ones you would like to accept.
Monitor de Diagnóstico 32" 8MP
Monitor de Diagnóstico 32" 8MP

Calidad de imagen Optimizada para
Revisado Diagnóstico
Para Aumentar la Eficiencia y
Comodidad
Todas las especificaciones
DIMENSIÓN/PESO
Peso con Peana [kg]
7
Peso sin Peana [kg]
5.6
Peso empaquetado [kg]
11.4
CARACTERÍSTICAS
HDR 10
NO
Efecto HDR
NO
Compatible con DICOM
Si
Tecla de acceso rápido
NO
Calibración HW
Calibración HW lista
Estabilizador de Brillos
Si
Sensor de LuzAutomático
NO
Protección anti-parpadeo
Si
Sensor de presencia
NO
Sensor frontal
NO
Modo de lectura
Si
Temperatura de Color
6500K/7500K/9300K/Manual(5000K~10000K)
Modo de patología
Si
Super Resolution+
Si
Modo de Rotación y Espejo
NO
Failover Input Switch
NO
Enfoque de vista
Si
Modo caja de luz
NO
Encendiendo
NO
Estabilizador de Negros
Si
PBP
2PBP
PIP
NO
Ahorro inteligente de energía
Si
POTENCIA
Tipo
Alimentación externa (adaptador)
Salida CC
19V, 3.42A
Entrada CA
100~240V (50/60Hz)
Consumo de potencia (Máx.)
65W
Consumo de potencia (DC apagado)
menos de 0.3W
STANDARD
KGMP
Si
KC (for Rep. of Korea)
NO
RoHS
Si
REACH
Si
WEEE
Si
MFDS
Si
IP (Frontal/Excepto frontal)
NO
Vandal-proof
NO
UL (cUL)
Si
IEC (IEC 60601-1 / IEC 60601-1-2)
Si
EN (EN 60601-1 / EN 60601-1-2)
Si
IEC (IEC 60950-1 / IEC 55032, 55024)
Si
EN (EN 60950-1 / EN 55032, 55024)
Si
CE
Si
FDA
Class II
ISO13485
Si
GMP
Si
CONECTIVIDAD
3G-SDI
NO
12G-SDI
NO
Compuesto (Resolución)
NO
S-Video
NO
Componente (Resolución)
NO
RS-232
NO
D-Sub
NO
DVI-D
NO
HDMI
SI (x1)
DisplayPort
SI (x2)
Thunderbolt
NO
Daisy Chain
NO
Puerto USB de Subida
SI(x1/ver2.0)
Puerto USB de Bajada
SI(x2/ver2.0)
Salida para Auriculares
NO
PANTALLA
Tamaño [Pulgada]
31.5
Resolución
3840 x 2160
Ratio de Aspecto
16:9
Tamaño del píxel [mm]
0.18159 x 0.18159
Brillo (Típ.)[cd/m²]
450
Gama de Color (Típ.)
DCI-P3 98% (CIE1976)
Color Bit
10bit (8bit+FRC)
Ratio de contraste(Típ.)
1300:1
Tratamiento superficial
Anti-reflejos
Tiempo de respuesta
5ms (GtG a máx. Velocidad)
Ángulo de visión (CR≥10)
178º(D/I), 178º(Arriba/Abajo)
APLICACIÓN SW
Qubyx
Si
LG Calibration Studio (True Color Pro)
NO
Control Dual
Si
MECÁNICO
Diseño sin Bordes
Diseño de 4 lados prácticamente sin bordes
Interruptor mecánico
NO
Soporte OneClick
Si
Ajustes de posición de la pantalla
Inclinación/Altura/Pivotable
Montaje en pared [mm]
100 x 100
ACCESORIO
Cable de alimentación
Si
Adaptador
Si
Hoja de calibración (Papel)
Si
DVI-D (Color/Largo)
NO
HDMI (Color/Largo)
Si
Cable de subida USB3.0
NO
D-Sub
NO
Display Port
Si
Data Sheets
Para obtener a más documentación técnica y otras descargas, visita la página LG B2B Partner Portal.